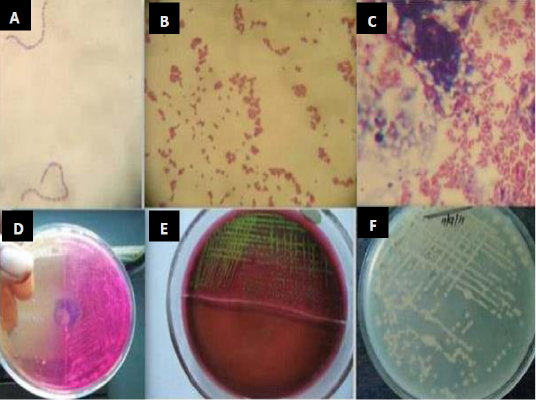
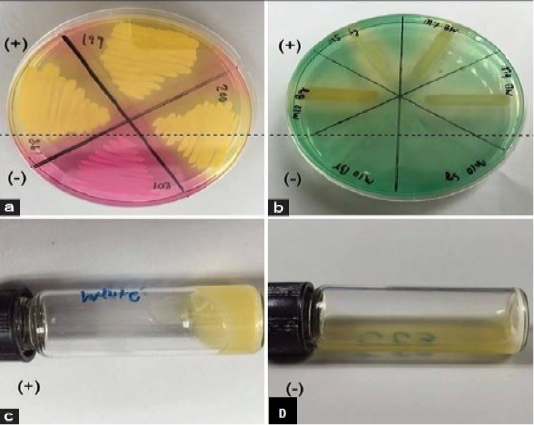
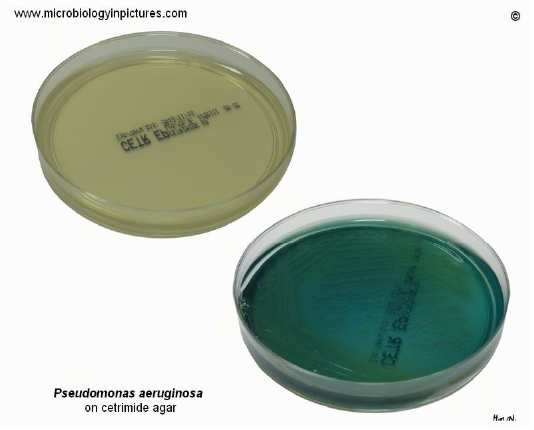
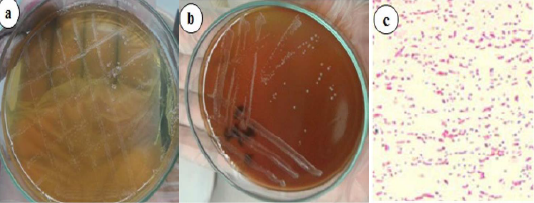

Journal of Animal Health and Production
Isolation and identification of Staphylococcus spp., Streptococcus and E. coli from bovine mastitic milk sample. (A) Streptococcus spp. (B) Staphylococcus spp. (C) Gram negative bacilli (D) colony growth on mannitol salt agar (E) metallic sheen on EMB agar by E. coli isolates (F) colonies on muller hinton agar (Mohanty et al., 2013).
Screening tests for identification of Staphylococcus aureus from subclinical bovine mastitic milk sample. mannitol salt agar (a): deoxyribonuclease test (b): tube coagulase test positive result (c) and coagulase test negative result (d) (Pumipuntu et al., 2017).
Cetrimide agar change its color from yellow to blue-green while showing growth of P. aeruginosa. Cultivation 24 hours at 37°C + 48 hours at room temperature (Banerjee et al., 2017).
Isolation of Mycobacterium bovis in stone brink media, yellowish and granular with a creamy appearance of M. bovis colonies (https://www.researchgate.net).
Microscopic image of Mycoplasma bovis colonies as fried eggs appearance (central dark zone surrounded by a lighter peripheral zone) (Ismael et al. 2018).
Brucella growth on selective agar media, blood agar media (a) Small, translucent, dewdrop-like round, and convex growth with smooth margins on Brucella selective agar media. (b) Whitish-grey, shiny, circular, convex, and nonhemolytic colonies of bacteria on blood agar media. (c) Gram-negative paired coccobacilli under a light microscope (400x) (Islam et al., 2018).
Milk ring test for detection of anti-Brucella IgM and IgA bound to milk fat globules. (Bhanu Rekha et al., 2015).